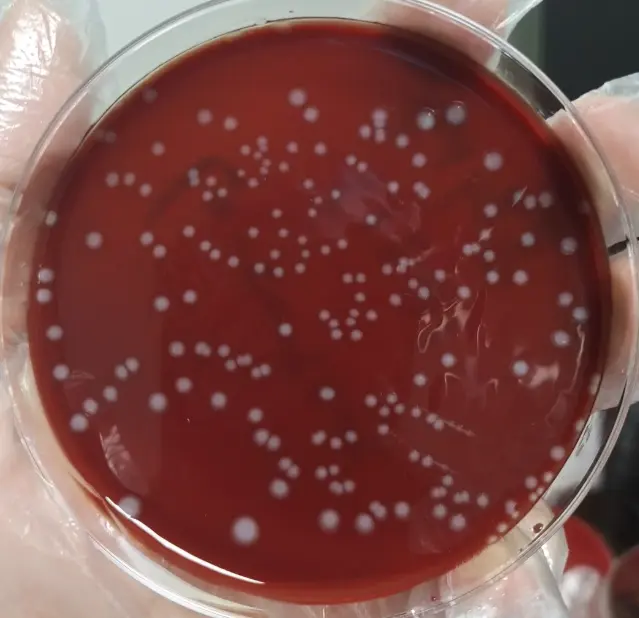
李斯特菌（Listeria）

单核细胞增生李斯特菌检测与防控全指南:破解嗜冷菌的食品安全威胁
发布时间:2026-03-06 浏览次数:84
李斯特菌(Listeria),特别是其最具致病性的菌种——单核细胞增生李斯特菌,是食品安全领域备受关注的病原体。它作为一种典型的嗜冷菌,能在4℃的冰箱冷藏环境中持续缓慢增殖,这使得常规的冷藏保鲜手段对其失效,对即食食品、乳制品等构成了持久威胁。本文将系统解析其生物学特性、标准检测方法(如GB 4789.30),并提供从实验室到厨房的全程防控指南。
一、李斯特菌概述与核心生物学特性
1. 形态与染色特征
李斯特菌为革兰氏阳性短杆菌,常呈单个、成对或特征性的V字排列。其无芽孢,但在20-25℃时依靠周生鞭毛运动活跃,此特性可用于初步鉴别(运动性试验)。细胞壁含有厚层肽聚糖和磷壁酸,革兰氏染色呈典型的蓝紫色。
2. 嗜冷性:低温生长的核心威胁
李斯特菌的生长温度范围极广(1-45℃),最适温度为30-37℃。然而,其最显著的危害特性在于嗜冷性:在4℃的冰箱环境中仍可繁殖。这意味着被污染的冷藏食品,如即食肉类、软奶酪、预切蔬果,在储存期间菌量可能不降反增,极大地增加了食源性感染的风险。
二、实验室培养与鉴定要点
1. 血琼脂平板上的菌落形态鉴别
在血琼脂平板上培养24-48小时后,李斯特菌可形成具有鉴别意义的菌落:
外观:直径约0.2-0.4mm,灰白色、半透明,边缘整齐,表面光滑湿润如露珠。
光泽:在斜射光下观察,菌落呈现独特的蓝绿色反光,这是一个重要的初步识别特征。
溶血性:菌落周围会产生一个狭窄但清晰的β溶血环,这是由李斯特菌溶血素O(LLO)引起的,是区分致病性单核细胞增生李斯特菌与其他李斯特菌属的关键指标之一。
2. 标准检测流程与生化鉴定
对于食品样本,需依据《食品安全国家标准 食品微生物学检验 单核细胞增生李斯特氏菌检验》(GB 4789.30) 进行操作。该标准规定了从增菌、分离到生化鉴定的完整流程。除溶血性外,典型的CAMP试验(协同溶血)和糖发酵试验(如七叶苷水解)也是重要的鉴定依据。现代实验室也常采用PCR快速检测方法或免疫学方法进行初筛和确认。
三、传播途径、风险人群与全程安全控制
2. 主要污染食品与传播媒介分析
李斯特菌广泛存在于土壤、水等自然环境,主要通过污染食品传播:
高风险食品:未经巴氏消毒的乳制品(如生奶、软质奶酪)、即食熟肉制品(如冷切肉、肉酱)、即食水产品、生食的瓜果蔬菜。
交叉污染源:厨房中的砧板、刀具、抹布、冰箱内壁等,若接触生食后未彻底清洁,极易成为二次污染源。
2. 高危人群针对性建议
感染李斯特菌后,健康成人可能症状轻微,但对特定人群危害极大:
孕妇:可能引发流产、死胎或新生儿严重感染。
老年人及免疫力低下者:可能导致败血症、脑膜炎等高死亡率疾病。
建议:上述人群应严格避免食用高风险食品,如冷藏的即食肉制品、软质奶酪,生食蔬果务必彻底清洗。
3. 从加工到餐桌的关键控制点
控制环节 | 核心措施 | 目标与原理 |
|---|---|---|
食品加工/储存 | 严格执行生熟分开;冰箱定期清洁消毒;高风险食品不长期冷藏。 | 防止交叉污染;消除冰箱内嗜冷菌滋生环境。 |
家庭烹饪 | 肉类、禽类等需彻底加热,确保中心温度超过70℃并维持足够时间。 | 热力可有效杀灭李斯特菌。 |
剩菜处理 | 剩余食物食用前需充分复热,不应仅简单回温。 | 杀灭可能在储存期间增殖的细菌。 |
个人与环境卫生 | 处理生食后彻底洗手;厨房用具、台面及时清洗消毒。 | 阻断经手和环境的传播链条。 |
四、常见问题解答(FAQ)
Q1: 李斯特菌在冰箱里能存活甚至生长多久?
A1: 李斯特菌在冰箱(4℃)环境中不仅能长期存活,还能缓慢增殖,时间可达数周甚至数月。因此,“冰箱保险”对其无效,定期清理冰箱并避免长期储存高风险食品至关重要。
Q2: 除了肉类和奶制品,还有哪些食物需要警惕?
A2: 预包装的沙拉、即食水果切片、熏制海产品、未经充分清洗的生食蔬菜都可能被污染。任何不经加热直接食用的食品都存在潜在风险。
Q3: 单核细胞增生李斯特菌的检测周期一般是多久?
A3: 依据GB 4789.30的传统培养鉴定方法,通常需要5-7天才能得出确认结果。目前许多检测机构提供更快速的PCR检测服务,可在24-48小时内提供初步结果,但阳性样本仍需传统方法确认。
Q4: 家庭厨房如何最有效地预防李斯特菌污染?
A4: 牢记三大原则:1) 生熟分离:使用不同的砧板和刀具;2) 彻底加热:确保食物中心熟透;3) 保持清洁:勤洗手,定期用热水或消毒剂清洁冰箱和厨房表面。
总结:应对单核细胞增生李斯特菌这一嗜冷性食源性致病菌,需要结合对其生物学特性的理解、规范的实验室检测方法(参考GB 4789.30标准)以及贯穿食品供应链和家庭消费环节的综合性防控措施。通过提高风险意识并落实关键控制点,能有效降低由其引发的食品安全风险。
